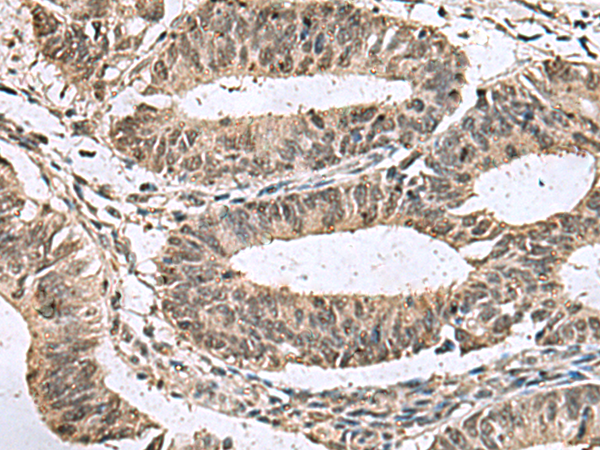

|
Background: |
This gene encodes a member of the disulfide isomerase (PDI) family of endoplasmic reticulum (ER) proteins that catalyze protein folding and thiol-disulfide interchange reactions. The canonical protein encoded by this gene has an N-terminal ER-signal sequence, a catalytically active thioredoxin domain, one transmembrane domain and a C-terminal ER-retention sequence. This gene is expressed in many tissues but has its highest expression in heart and skeletal muscle. It is expressed in the retinal neuroepithelium and lens epithelium in the developing murine eye and haploinsufficiency of this gene in humans and zebrafish is associated with microphthalmia. Alternative splicing results in multiple transcript variants encoding distinct isoforms. |
|
Applications: |
ELISA, IHC |
|
Name of antibody: |
TMX3 |
|
Immunogen: |
Fusion protein of human TMX3 |
|
Full name: |
thioredoxin related transmembrane protein 3 |
|
Synonyms: |
PDIA13; TXNDC10 |
|
SwissProt: |
Q96JJ7 |
|
ELISA Recommended dilution: |
5000-10000 |
|
IHC positive control: |
Human colorectal cancer and Human liver cancer |
|
IHC Recommend dilution: |
50-200 |

購(gòu)物車(chē)
購(gòu)物車(chē) 幫助
幫助
 021-54845833/15800441009
021-54845833/15800441009
